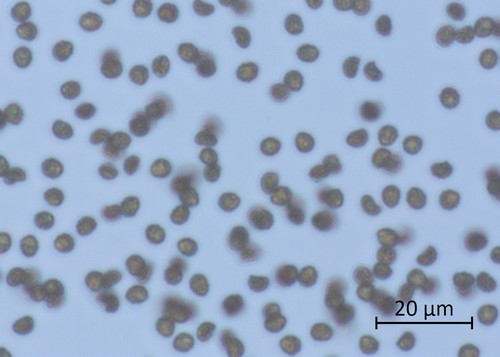

Back Search Sitemap MycoBank IndexFung Gymnopilus bellulus
Kleinsporiger Flämmling
aktualisiert: 25.11.2023 12:04:06
Autoren:
(Peck) Murrill
Klassifikation:
Fungi, Dikarya, Basidiomycota, Agaricomycotina, Agaricomycetes, Agaricomycetidae, Agaricales, Agaricineae, Strophariaceae, Gymnopilus
Aktueller Name gem. MycoDB
Current name: Gymnopilus bellulus (Peck) Murrill, N. Amer. Flora 10 (3): 200 (1917) [MB#355881]
Basionym: Obligate synonyms: Taxonomic synonyms:
Im Mikroskop fallen sofort die äusserst kleinen aber grobwarzigen Sporen auf.
"
"
Verwechslungsmöglichkeiten
"
Galerina cinctula hat grobwarzige Sporen, die Masse sind aber gemäss Funga Nordica mit 10,5 -12,5 µm grösser.
"
Galerina walleyniana, welche in Erhard Ludwig: Sporenmasse von (5)6-7(7,5) x, 3,5-4(4.5) liegt auch wesentlich darüber. Auch sind die Sporen nicht dextrinoid
"
Gymnopilus subsphaerosporus: Mit subglobosen Sporen
Fruchtkörper / Habitus / Wachstumsform
Klein bis 2cm
Sporenfarbe / Sporenpulver (Abwurf)
Abwurf braun
Sporenmasse
4.6 - 5.8 x 3.2 - 3.8 µm - Q: 1.33 - 1.75 (Ø LxB: 5.2 x 3.4 µm ØQ:1.5 AzM: 25)
Sporenform
Breitelliptisch
Cheilozystiden
Tibiiform
Schnallen
Vorhanden
Melzers-Reagenz
Sporen nicht dextrinoid
Gattung/en:
Pilzporträt JPG
Suchbegriffe / Tags: Galerina walleyniana, tbiiforme Zystiden
Exsikkat verfügbar
Gymnopilus bellulus - Flammer, T© 13123
Gymnopilus bellulus - Flammer, T© 13342
Gymnopilus bellulus - Flammer, T© 13343
Gymnopilus bellulus - Flammer, T© 13124
Gymnopilus bellulus - Spore/n - Kongorot - Flammer, T© 13125
Gymnopilus bellulus - Flammer, T© 13133
Gymnopilus bellulus - Flammer, T© 13126
Gymnopilus bellulus - HDS - Flammer, T© 13127
Gymnopilus bellulus - Sporenabwurf / Sporenfarbe - Flammer, T© 13132